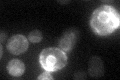
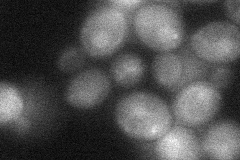

View description
Catalytic subunit of the histone acetyltransferase complex (NuA4) that acetylates four conserved internal lysines of histone H4 N-terminal tail; required for cell cycle progression and transcriptional silencing at the rDNA locus
Localization:
Intensity:
Fold change:
Significance:
-
C’ GFP library in SD
ER33.52 -
N' NOP1pr-GFP in SD

cytosol,nucleus45.0354 -
N' TEF2pr-mCherry in SD

cytosol,nucleus0 -
N' NATIVEpr-GFP in SD

nucleus22.3493 -
N' TEF2pr-VC and Cyto-VN in SD
cytosol,nucleus35.7127 -
C’ GFP library in SD+DTT

ER21.550.64Yes -
C’ GFP library in SD+H2O2

ER25.30.75No -
C’ GFP library in Starvation Media

ER19.550.58Yes -
C’ GFP library on the background of Pup2-DaMP

ER -
C’ GFP library on the background of CCT mutant

ER30.86060.920371No
